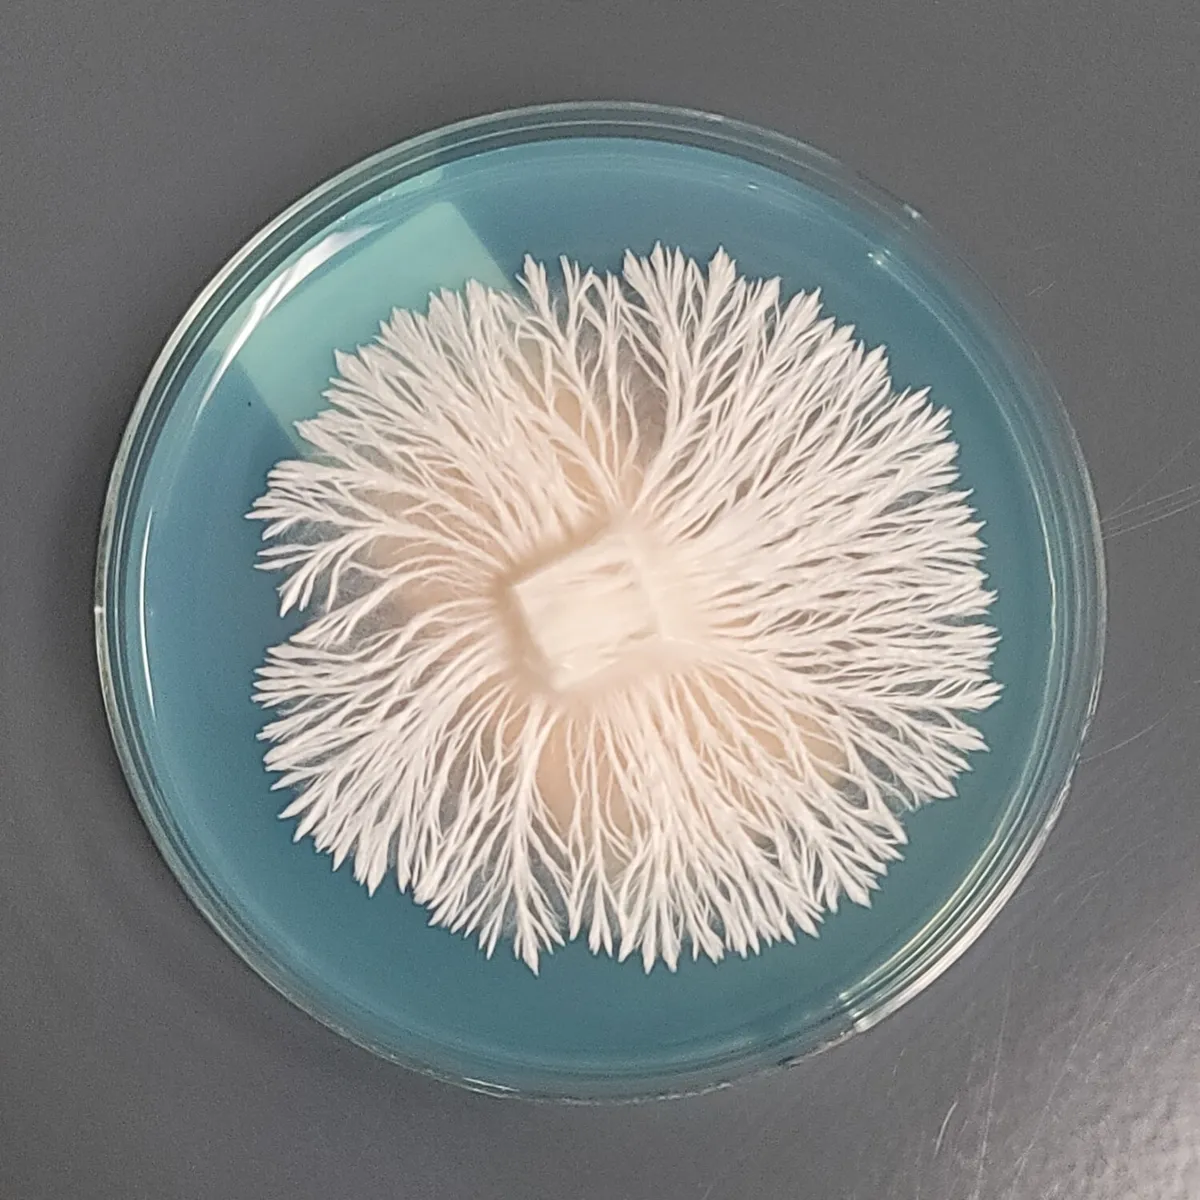
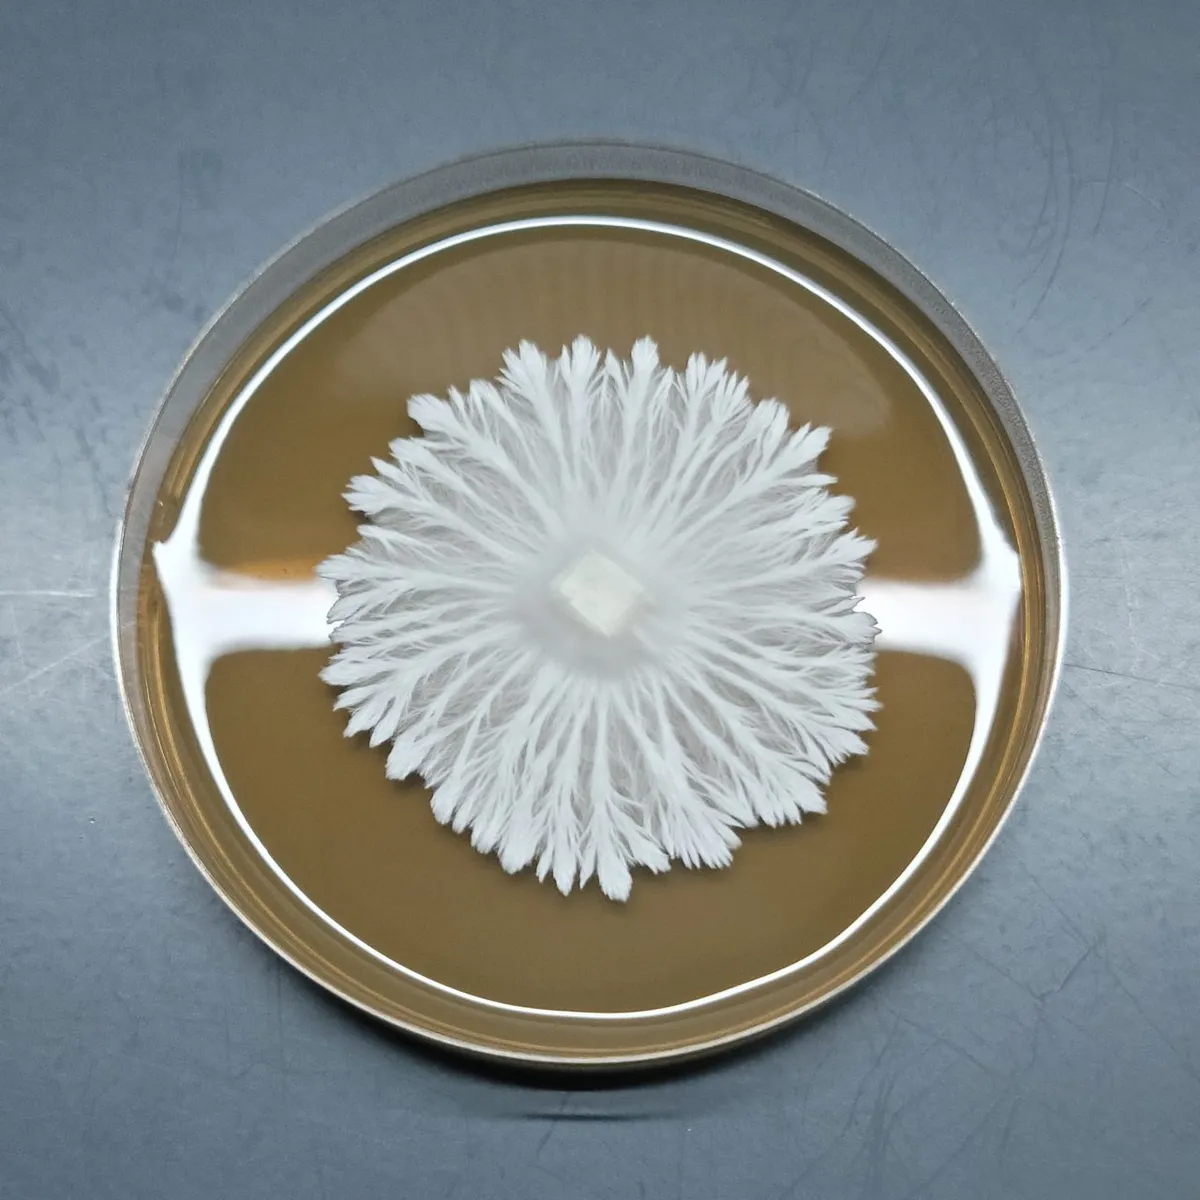
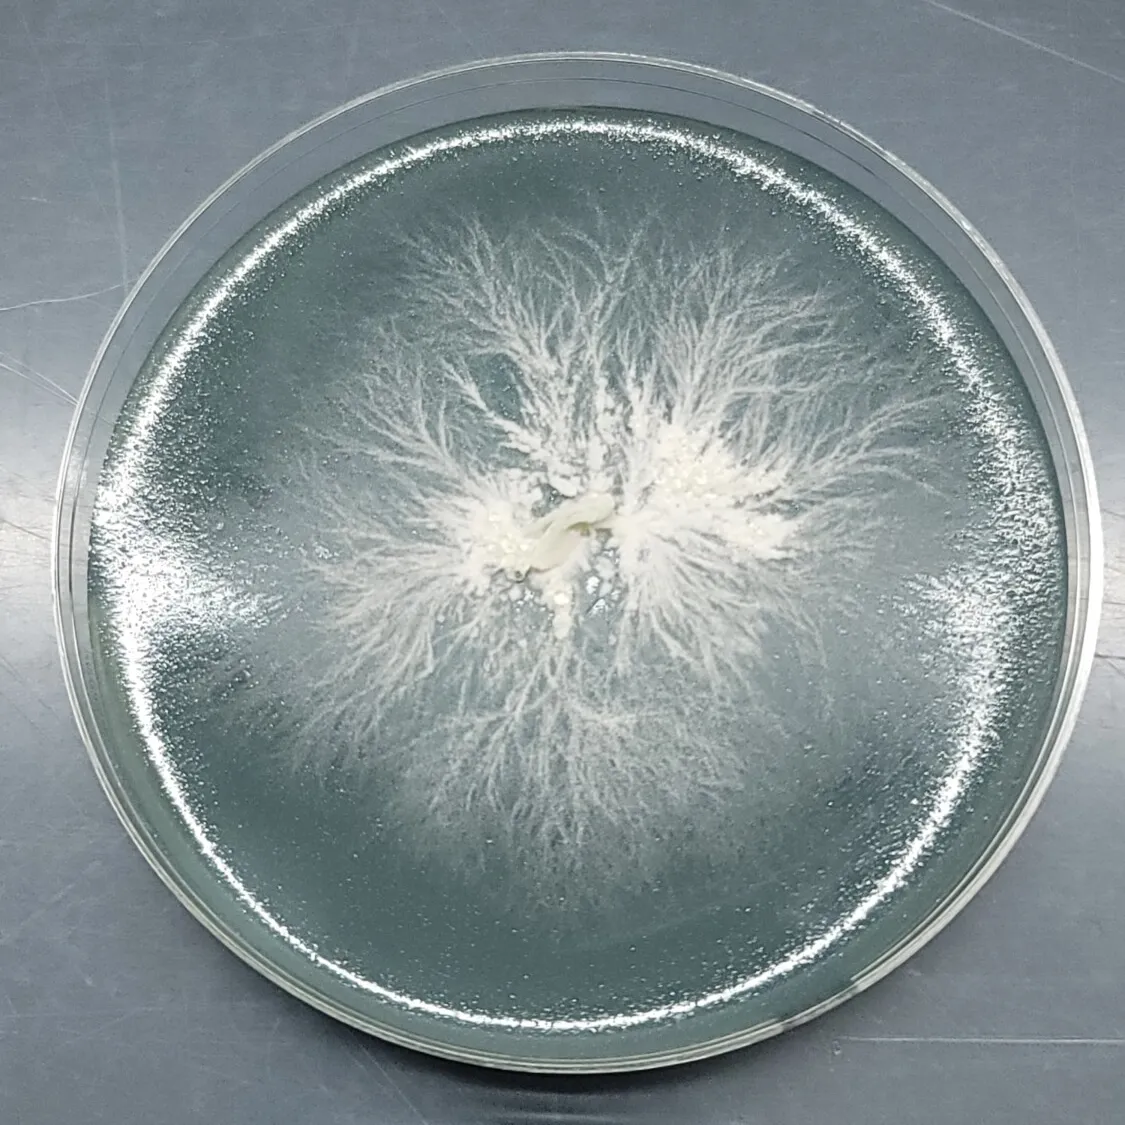

Mycelium Works: Unveiling the Hidden World of Mushroom Mycelium
The Hidden world of fungi
Mycelium Frequently Asked Questions
1. What is mycelium, and how is it different from mushrooms?
Mycelium is the main body of a fungus, made of fine white threads called hyphae. It grows through soil, wood, and other organic matter, breaking down nutrients. Mushrooms are the fruiting bodies, the part of the fungus that produces and releases spores. In simple terms, mycelium is like the roots, while mushrooms are the fruit.
2. Where does mycelium live and how does it grow?
Mycelium lives in soil, rotting wood, compost, and other natural substrates. It spreads by sending out microscopic hyphae that branch, fuse, and form vast underground fungal networks. These networks can connect entire ecosystems, supporting both fungi and plants.

3. What role does mycelium play in ecosystems?
Mycelium acts as nature’s recycler. It breaks down organic matter into nutrients that feed plants and enrich soil. Many fungi also form mycorrhizal partnerships with plants, delivering water and minerals to roots in exchange for sugars, creating one of the most important symbiotic relationships on Earth.


4. Can you see mycelium without a microscope?
Yes. Mycelium often looks like white, fuzzy threads or a cottony mat spreading through soil, wood, or decaying matter. While a microscope reveals the fine details of hyphae, mycelium is visible to the naked eye once it colonizes a surface.
5. Why is mycelium important for humans?
Mycelium is vital for both the environment and people. It is used in food (cheese, tempeh, and fermented products), medicine (antibiotics, supplements), agriculture (soil health and bioremediation), and even new industries like mycelium leather, packaging, and building materials. Its potential applications are expanding rapidly, making it one of the most exciting fields in fungal research.
Resource to Support Health & Medicine applications
- Venturella, G. et al. (2021). Medicinal Mushrooms: Bioactive Compounds, Use, and Health Effects — Clinical and In-Vivo Studies. Frontiers in Pharmacology.
This review covers how mushroom extracts and bioactive compounds (often from fruiting bodies or mycelium) are studied in lab and clinical settings for their immune, antioxidant, anti-inflammatory, and antimicrobial properties.

Is mycelium the largest living organism on Earth?
In Oregon’s Blue Mountains, a single fungal network spans an estimated 2,384 acres (965 hectares) of soil. To put that in perspective, this living organism covers nearly four square miles (10 square kilometers) — the equivalent of about 1,665 football fields.
Scientific American article: “Strange but True: The Largest Organism on Earth Is a Fungus” — about Armillaria ostoyae

Can mycelium communicate or share information?
Many readers have heard about the “Wood Wide Web” and wonder if mycelium can send signals, nutrients, or even “messages” between plants.
Can mycelium communicate or share information?
Many readers have heard about the “Wood Wide Web” and wonder if mycelium can send signals, nutrients, or even “messages” between plants.

Can mycelium survive without producing mushrooms?
This lets you explain how fungi can persist underground for years, even without fruiting, as long as the mycelium network is alive.
Mycelium challenges us to rethink what life looks like. It doesn’t have leaves, bark, or fur, yet it connects ecosystems, supports plants, and influences the health of entire forests. For mycologists and curious minds alike, studying mycelium is a way of uncovering the hidden architecture of the natural world, one hypha at a time








